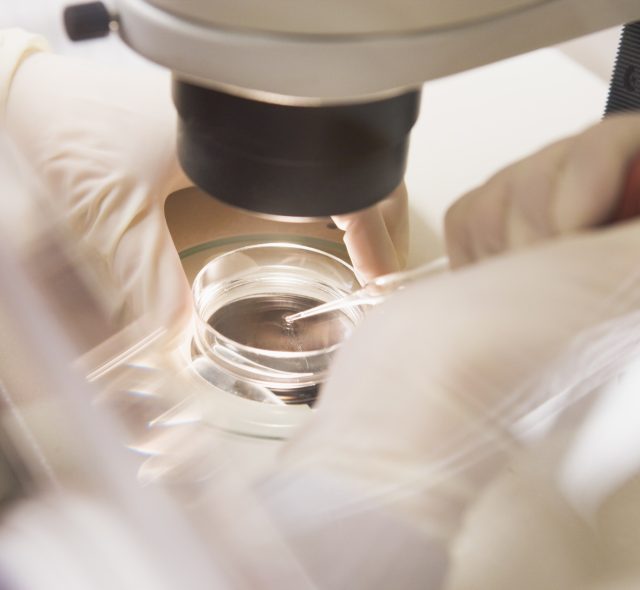

Più smart working, più figli? Basta un giorno
Il lavoro da casa non è più un capitolo di welfare aziendale. Sta entrando, senza chiedere permesso, nel dossier più ostico per governi e imprese: le nascite. Un gruppo di
In Italia, ogni giorno... | dati Istat (2024)
Perché l’empowerment femminile non basta più? Serve l’”Empoderamento”
L’8 marzo non può più essere solo una ricorrenza celebrativa o simbolica. Mentre il World Economic Forum avverte che, al ritmo attuale, occorreranno ben 123 anni per raggiungere l’equità di
Adnkronos Q&A, ‘Demografia, un patto fra generazioni’: l’evento il 24 giugno
Come affrontare le conseguenze dell’andamento della demografia? La scarsa natalità e l’invecchiamento della popolazione sono trend ormai consolidati. Per invertirli servono decenni. Intanto, è necessario investire per adeguare il mercato del lavoro e le pensioni,
FERTILITÀ
Super ager, gli over 80 con memoria da giovani: nei loro cervelli più neuroni “nuovi”
Hanno più di ottant’anni e una memoria che continua a funzionare come quella di persone molto più giovani. Ricordano parole, conversazioni e dettagli del passato con una precisione che sorprende
Vietato il porno in Australia agli under 18, ma un sistema aggira la norma
L’Australia ha ufficialmente lanciato una delle strette più severe al mondo sull’accesso ai contenuti per adulti. Da lunedì 9 marzo 2026, è entrata in vigore una normativa che obbliga i siti pornografici, i servizi di
Le donne cilene sfidano il governo di destra di Kast
A Santiago del Cile, le strade si sono tinte di verde e viola in occasione della Giornata Internazionale della Donna, trasformandosi nel palcoscenico di una delle più imponenti manifestazioni degli ultimi anni. Circa mezzo milione